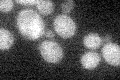
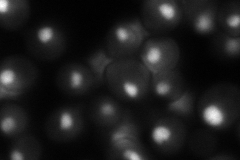

View description
RNA polymerase II second largest subunit B150, part of central core; similar to bacterial beta subunit
Localization:
Intensity:
Fold change:
Significance:
-
C’ GFP library in SD
below threshold15.28 -
N' NOP1pr-GFP in SD

punctate,nucleus239.112 -
N' TEF2pr-mCherry in SD

nucleus85.4434 -
N' NATIVEpr-GFP in SD
nucleus120.386 -
N' TEF2pr-VC and Cyto-VN in SD

nucleus49.6653 -
C’ GFP library in SD+DTT

technical problem0N/ANo -
C’ GFP library in SD+H2O2

cytosol17.051.11No -
C’ GFP library in Starvation Media

cytosol16.241.06No -
C’ GFP library on the background of Pup2-DaMP

below threshold -
C’ GFP library on the background of CCT mutant

below threshold15.81651.03495No
